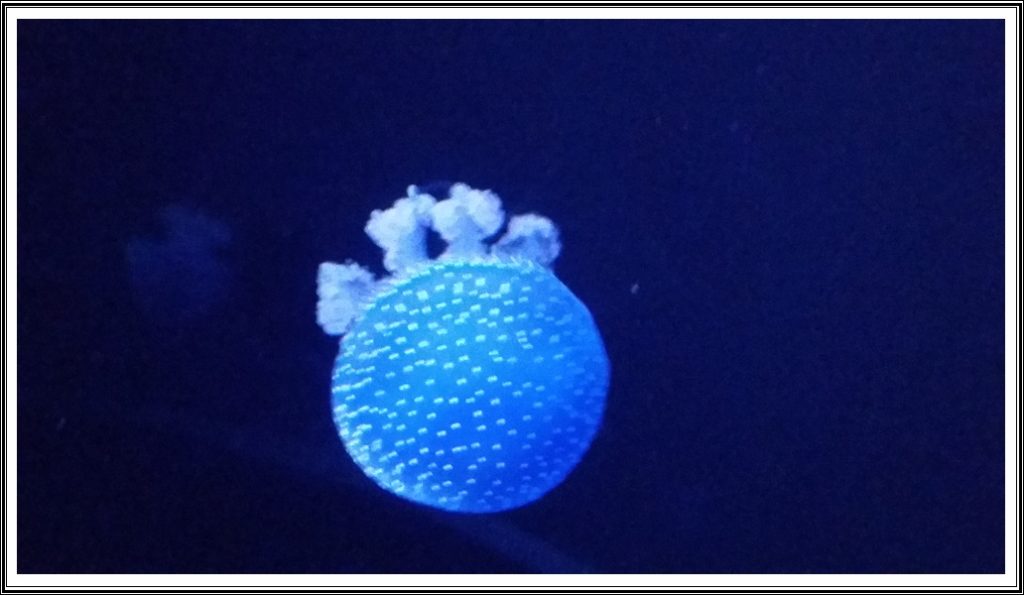
Portugal087 e1535255009109

ಆಗೋಸ್ತಾಚ್ಯಾ ಸ ತಾರಿಕೆರ್ ಸೊಮಾರಾ ಅಮ್ಚ್ಯಾ ಪೂರ್ವಜಾಂಕ್ ಕ್ರೀಸ್ತಾಂವ್ ಕೆಲ್ಲ್ಯಾ ಪೋರ್ಚುಗೀಸಾಂಕ್ ಮೆಳೊಂಕ್ ಅಮಿ ಡಬ್ಲಿನ್ ವಿಮಾನ್ ನಿಲ್ದಾಣಾ ಥಾವ್ನ್ ಬಾಯ್ರ್ ಸರ್ಲ್ಯಾಂವ್. ಚಡುಣೆ ತೀನ್ ಘಂಟ್ಯಾಚ್ಯಾ ವಿಮಾನ್ ಪಯ್ಣಾನ್ ವರ್ನ್ ಪಾಯ್ಲೆಂ ಆಮ್ಕಾಂ ಪೋರ್ಚುಗಲ್ಚ್ಯಾ ರಾಜಧಾನಿ ಲಿಸ್ಬನಾಕ್. ಥಂಯ್ ಥಾವ್ನ್ ಎಕಾ ಘಂಟ್ಯಾಚ್ಯಾ ಬಸ್ಸ್ ಪಯ್ಣಾನ್ ಅಮ್ಕಾಂ ಪಾಯ್ಲೆಂ ಮರಿ ದಿಶ್ಟಿಕ್ ಪಡ್ ಲ್ಲೊ ಪವಿತ್ರ್ ಜಾಗೊ ಫಾತಿಮಾಕ್. ಹೊಟೇಲ್ ಆಲೆಲುಯಾನ್ ಆಮ್ಕಾಂ ಬರೊಚ್ಚ್ ಯೆವ್ಕಾರ್ ಮಾಗ್ಲೊ. ಥಂಯ್ಸರ್ ಆಮ್ಚ್ಯಾ ಕುಡಿಚಿ ನಿತಾಳಾಯ್ ಸಂಪವ್ನ್ ಪಾವ್ಲ್ಯಾಂವ್ ಆಮಿ ಫಾತಿಮಾ ಬೆಸಿಲಿಕಾಚ್ಯಾ ಮಿಸಾಚ್ಯಾ ಬಲಿಧಾನಾಕ್.

















ಫಾತಿಮಾ ಏಕ್ ಭೊವ್ ಚ್ಚ್ ಪವಿತ್ರ್ ಜಾಗೊ. 1917 ಮಾಯ್ ಮಹಿನ್ಯಾಚ್ಯಾ ತೆರಾ ತಾರಿಕೆರ್ ಲುಸಿಯಾ, ಫ಼್ರಾನ್ಸಿಸ್ಕೊ ಆನಿ ಜೆಸಿಂತಾ ಮ್ಹಳ್ಳ್ಯಾ ತೆಗಾಂ ನೆಂಟ್ಯಾ ಭುರ್ಗ್ಯಾಂಕ್ ಮರಿ ಹಾಂಗಾಸರ್ ದಿಶ್ಟಿಕ್ ಪಡ್ ಲ್ಲಿ. ವಿಸ್ತಾರ್ ಮೈದಾನಾರ್ ಅಸ್ಚಿ ಹಿ ಬೆಸಿಲಿಕಾ ಸದಾಂನೀತ್ ಹಜಾರೊಂ ಲೋಕಾಕ್ ಸ್ವಾಗತ್ ಕರ್ತಾ. ಮೀಸ್ ಆಯ್ಕೊನ್, ವಾತಿ ಪೆಟವ್ನ್, ಸಮೇಸ್ತಾಂ ಖಾತಿರ್ ಮಾಗೊನ್, ಇಮಾಜಿ, ಕೊಂತಾ ಆನಿ ಆಗ್ಮೆಂತ್ ಘೆವ್ನ್ ಬಾಯ್ರ್ ಸರ್ಲ್ಯಾಂವ್ ಅಮಿ ಪಾಟಿಂ ಹೊಟೇಲ್ ಆಲೆಲುಯಾಕ್. ಸಾಂಜೆರ್ ತೆಣೆಂ – ಹೆಣೆಂ ಇಲ್ಲೆಂ ಭಂವೊನ್ ಉಪ್ರಾಂತ್ ಸಾಂಜೆಚೆಂ ಜೆವಾಣ್ ತಿರ್ಸುನ್ ಖಟ್ಲ್ಯಾಕ್ ತೆಂಕ್ಲ್ಯಾಂವ್.

ದುಸ್ರೆ ದೀಸ್ ಸಕಾಳಿಂ ಉಟೊನ್ ಥಂಯ್ಚ್ ಹೊಟೇಲಾಂತ್ ನಾಸ್ಟೊ ಕರ್ನ್ ಬಸ್ಸ್ ದರ್ನ್ ಪಾವ್ಲ್ಯಾಂವ್ ಅಮಿ ಲಿಸ್ಬನಾಕ್. ಸಂಸಾರಾಂತ್ ದುಸ್ರೆಂ ಸ್ಥಾನ್ ಜೊಡ್ ಲ್ಲೆಂ ಅಕ್ವೆರಿಯಮ್ ಜಾವ್ನಾಸ್ ಲ್ಲ್ಯಾ ಓಶೆನೆರಿಯಮಾಕ್. ಆಡೇಜ್ ಘಂಟೊ ಥರ್ ಥರಾಚ್ಯಾ ಮಾಸ್ಳ್ಯಾಂಕ್ ಪಳೆವ್ನ್ ಉಪ್ರಾಂತ್ ದೊನ್ಪಾರಾಂಚೆ ಜೆವಾಣ್ ಸಂಪವ್ನ್ ಕೇಬಲ್ ಕಾರಾಂಚೆರ್ ಬಸೊನ್ ಮೊಳ್ಬಾಚೆರ್ ಉಬೊನ್ ಸಗ್ಳೆಂ ಲಿಸ್ಬನ್ ದರ್ಶನ್ ಕೆಲೆಂ. ಉಪ್ರಾಂತ್ ಅಮಿ ಸಾಂತ್ ಅಂತೊನಿ ಜಲ್ಮಾಲ್ಲ್ಯಾ ಜಾಗ್ಯಾಕ್ ಪಾವ್ಲ್ಯಾಂವ್. ಮಾಗ್ಣೆಂ, ಮೀಸಾಂ ಆನಿ ವಾತಿ ಪೆಟೊವ್ನ್ ಥಂಯ್ ಥಾವ್ನ್ ರೈಲ್ ನಿಲ್ದಾಣಾಕ್ ಪಾವ್ಲ್ಯಾಂವ್.

























ಸಾಂಜೆರ್ ಅಮ್ಕಾಂ ರೈಲ್ ದರ್ನ್ ಆಲ್ಬುಫ಼ೆರಾ ವಚೊಂಕ್ ಅಸ್ಲೆಂ. ರೈಲಾರ್ ತೀನ್ ಘಂಟ್ಯಾಚೆಂ ಪಯ್ಣ್ ಸಂಪಯ್ಲ್ಯಾ ಉಪ್ರಾಂತ್ ಅಮ್ಕಾಂ ’ಬಲಯಾ’ ಮ್ಹಣ್ ಹೊಟೇಲಾನ್ ಆಪಯ್ಲೆಂ. ರಾತ್ಚ್ಯಾ ಇಕ್ರಾ ವರಾಂಚೆರ್ ಅಮ್ಚಿ ಟ್ಯಾಕ್ಸಿ ಹೊಟೇಲ್ ’ಬಲಯಾ ಅಟ್ಲಾಂಟಿಕೊ’ ಮುಕಾರ್ ಥಾಂಬ್ಲಿ. ಹ್ಯಾ ರಾತ್ಚ್ಯಾ ವೆಳಾರ್ ಪಿಯೆಂವ್ಕ್ ಸೊರೊ ದರಬಸ್ತ್ ಆಸ್ಲೊ ತರೀ ಕೊಕೊ ಮುಗ್ದಾಲ್ಲೊ. ಹ್ಯಾ ವೆಳಾ ಪಿಜ್ಜಾನ್ ಅಮ್ಚ್ಯಾ ಪೊಟಾಚಿ ಭುಕ್ ಥಾಂಬಯ್ಲಿ.
ಬುದ್ವಾರಾ ದೀಸಾ ಸಕಾಳಿಂ ಉಟೊನ್ ನಾಸ್ಟೊ ತಿರ್ಸುನ್ ಸ್ವಿಮ್ಮಿಂಗ್ ಪೂಲಾಕ್ ಉಡ್ಕಿ ಮಾರ್ಲಿ. ಥೊಡಿಂ ವ್ಹರಾಂ ವಿರಾಮ್ ಕೆಲ್ಯಾ ಉಪ್ರಾಂತ್ ನಾವ್ನ್ ನಿತಳ್ ಜಾವ್ನ್ ದೊನ್ಪಾರಾಂಚೆಂ ಜೆವಣ್ ಕರ್ನ್ ಆಲ್ಬುಫ಼ೆರಾ ಸಿಟಿ ಪಳೆಂವ್ಕ್ ಭಾಯ್ರ್ ಸರ್ಲ್ಯಾಂವ್. ಆಲ್ಬುಫ಼್ಹೆರಾ ಬೀಚ್ ಬೊವ್ ಚ್ಚ್ ಸೊಬಿತ್. ತಾಚ್ಯಾ ತಡಿರ್ ವಸ್ತಿ ಕರ್ನ್ ಅಸಾ ಓಲ್ಡ್ ಟೌನ್ ಮ್ಹಣ್ ನಾಂವಾಡ್ ಲ್ಲೆಂ ಸೊಬೀತ್ ಸುಂದರ್ ಶಹರ್. ತ್ಯಾ ದೀಸ್ ಕಠೀಣ್ ವೊತಾಕ್ ರಾನಾಕ್ ಉಜೊ ಲಾಗೊನ್ ದುಂವೊರ್ ಸಗ್ಳ್ಯಾ ಮೊಳ್ಬಾರ್ ವಿಸ್ತಾರ್ ಲ್ಲೊ ಆನಿ ವಾರ್ಯಾಕ್ ಗೊಬೊರ್ ಉಬ್ತಾಲೊ ದೆಕುನ್ ತ್ಯಾ ದಿಸಾ ತ್ಯಾ ಬೀಚಾಚೆಂ ದ್ರಶ್ಶ್ ಚ್ಚ್ ವಿಂಗಡ್ ಜಾವ್ನಾಸ್ ಲ್ಲೆಂ. ರಾಗಾನ್ ಪೆಟ್ ಲ್ಲ್ಯಾ ಬರಿಂ ದಿಸ್ಚೊ ತೊ ತಾಂಬ್ಡೊ ಸುರ್ಯೊ, ದುಂವೊರ್ ಬರ್ ಲ್ಲ್ಯಾ ಮೊಳ್ಬಾಚೆಂ ಪ್ರತಿಫಲನ್ ಜಾವ್ನ್ ಉದ್ಕಾಚೊ ರಂಗ್ ಕಾಳೊ ಜಾಲ್ಲೊ. ಆಮಿ ಥೊಡೊ ವೇಳ್ ಥಂಯ್ಚ್ ಖರ್ಚುನ್ ಉಪ್ರಾಂತ್ ಸಾಂಜೆಚೆ ಪೊಟಾಕ್ ಘಾಲ್ನ್ ಥಂಯ್ ಥಾವ್ನ್ ಪಾಟಿಂ ಅಮ್ಚ್ಯಾ ಹೊಟೇಲಾಕ್ ಯೇವ್ನ್ ಪಾವ್ಲ್ಯಾಂವ್.













































ಉದೆಲ್ಲೊ ದೀಸ್ ಬ್ರೇಸ್ತಾರ್. ಭುರ್ಗ್ಯಾಂಚ್ಯಾ ಮೊಗಾಚೊ ದೀಸ್. ಸಗ್ಳೊ ದೀಸ್ ಆಮಿ ಉದ್ಕಾ ಖೆಳಾಂತ್ ಖರ್ಚುಂಚಿ ಯೆವ್ಜಣ್ ಕೆಲ್ಲಿ. ಸಕಾಳಿಂ ಸಾಡೆ ನೋವಾಂಕ್ ಸ್ಲೈಡ್ ಆನಿ ಸ್ಪ್ಲ್ಯಾಶ್ ವಾಟರ್ ಪಾರ್ಕಾಕ್ ಅಮ್ಕಾಂ ಆಪವ್ನ್ ವರುಂಕ್ ಬಸ್ಸ್ ತಯಾರ್ ಆಸ್ಲೆಂ. ಎಕಾ ಘಂಟ್ಯಾಚಿ ವಾಟ್ ಜಾಲ್ಲ್ಯಾನ್ ಆಮಿ ಕೊಂಕ್ಣಿ, ಕನ್ನಡ, ಹಿಂದಿ ಆನಿ ತಶೆಂಚ್ಚ್ ಭುರ್ಗ್ಯಾಂ ಖಾತಿರ್ ಇಂಗ್ಲಿಶ್ ಅಂತ್ಯಾಕ್ಷರಿ ಸುರು ಕೆಲಿ. ಸವಾಯ್ ಧಾ ವ್ಹರಾರ್ ಪಾವ್ಲ್ಯಾಂವ್ ಆಮಿ ಉದ್ಕಾ ಸಂಸಾರಾಕ್. ವಯ್ರ್ ಥಾವ್ನ್ ಸುರ್ಯಾಚ್ಯಾ ಕಠೀಣ್ ಕೀರ್ಣಾಂಕ್ ಕರ್ಪಾಲ್ಯಾರೀ ಥಂಡ್ ಉದಾಕ್ ಆಮ್ಚ್ಯಾ ಜೀವಾಕ್ ಥಂಡಾಯ್ ದಿತಾಲೆಂ. ಎಕಾ ಘಡಿಯೆಚ್ಯಾ ಸ್ಲೈಡಾ ಖಾತಿರ್ ದೊದೊನ್ ಘಂಟೆ ಲೈನಿರ್ ರಾವಾಜಯ್ ಪಡ್ತಾಲೆಂ. ತ್ಯಾ ಪಾರ್ಕಾಂತ್ ಚಡುಣೆ ಪಾಂಚ್ ಹಜಾರ್ ಲೋಕ್ ಜಮ್ ಲ್ಲೊ. ತೊ ದೀಸ್ ಪಾಶಾರ್ ಜಾಲ್ಲೊಚ್ಚ್ ಕಳ್ಳೊನಾ.
ಸುಕ್ರಾರಾ ದಿಸಾ ಆಲ್ಗಾರ್ವ್ ಮ್ಹಲ್ಳೊ ಅನ್ಯೇಕ್ ಗಾಂವ್ ಪಳೆಂವ್ಕ್ ಭಾಯ್ರ್ ಸರ್ಲ್ಯಾಂವ್. ಶೊಪಿಂಗ್ ಸೆಂಟಾರಾಂತ್ ಶೊಪಿಂಗ್ ಕರ್ನ್, ಜೆವಾಣ್ ತಿರ್ಸುನ್ ಇಲ್ಲೊ ಗಾಂವ್ ಭೊವೊನ್ ಆಮಿ ಪಾಟಿಂ ಪರ್ತಾಲ್ಯಾಂವ್.


ಸನ್ವಾರಾಚೊ ದೀಸ್ ವಿರಾಮಾಚೊ ದೀಸ್ ಜಾವ್ನಾಸ್ ಲ್ಲೊ. ಸಗ್ಳೊ ದೀಸ್ ಆಮಿ ಹೊಟೇಲಾಚ್ಯಾ ಪೂಲಾಂತ್, ಜ್ಯಾಕೂಝಿಂತ್ ಅನಿಂ ಸ್ಟೀಮ್ ರೂಮಾಂತ್ ಖರ್ಚಿಲೊ. ಸಾಂಜೆರ್ ಅಮಿ ಪೋರ್ಚುಗಲ್ಚೆಂ ಲಾಸ್ಟ್ ಸಪ್ಪರ್ ಸೆಂವ್ಕ್ ಎಕಾ ಇಂಡಿಯನ್ ರೆಸ್ಟೊರೆಂಟಾಕ್ ಪಾವ್ಲ್ಯಾಂವ್. ಸ್ವಾದಿಕ್ ನಾನ್ ಪಾಂವ್ ಆನಿ ಕುಂಕಾಡ್ ಆನಿ ಝಿಂಗಾ ಮಸಾಲಾ ಆನಿ ಜೀರಾ ರೈಸ್, ಪುಲಾವ್ ರೈಸ್ ಜೇವ್ನ್ ಪರ್ತಾಲ್ಯಾಂವ್ ಪಾಟಿಂ ಹೊಟೇಲಾಕ್.
ಉದೆಲ್ಲೊ ಆಯ್ತಾರಾಚೊ ದೀಸ್ ಪೊರ್ಚುಗಲಾಕ್ ಬೈ ಬೈ ಕರ್ಚೊ. ಸಕಾಳಿಂಚೊ ನಾಸ್ಟೊ ತಿರ್ಸುನ್ ಅಮ್ಚ್ಯಾ ಜಡಾಯೆಚ್ಯಾ ಲಗ್ಗೆಜಿ ಸಾಂಗಾತಾ ಜಡಾಯೆಚೆಂ ಕಾಳಿಜ್ ಘೆವ್ನ್, ಬಾರಾಧೀಕ್ ಮೆಟಾಂ ಕಾಡ್ನ್ ಆಮ್ಕಾಂ ವಿಮಾನ್ ನಿಲ್ದಾಣಾಕ್ ವರೊಂಕ್ ಆಯಿಲ್ಲ್ಯಾ ವಡ್ಲ್ಯಾ ಸಯ್ತ್ ಬಸ್ಸಾಚೆರ್ ಚಡ್ಲ್ಯಾಂವ್. ಸಗ್ಳ್ಯಾಂಚಿ ಮುಖಮಳಾಂ ಬಾವ್ ಲ್ಲಿಂ ಪ್ರತ್ಯೇಕ್ ಜಾವ್ನ್ ಭುರ್ಗ್ಯಾಂಚಿ. ಪೊರ್ಚುಗಲಾಕ್ ಆದೇವ್ಸ್ ಮಾಗೊನ್ ವಿಮಾನ್ ಆಮ್ಕಾಂ ಘೆವ್ನ್ ಉಬ್ಲೆಂ ಡಬ್ಲಿನಾಚಿ ವಾಟ್ ದರ್ನ್.
► ಮೊನಿಕಾ ಮಥಾಯಸ್ ಡಬ್ಲಿನ್





Very informative article, Keep writing Monica Bai.
Nice Article
ಬರೆಂ ಕರ್ನ್ ವರ್ಣಿಲಾಂ… ತರೀ ಅನೀಕೀ ಚಿಕ್ಕೆಂ ಥಂಯ್ಚ್ಯಾ ಜಾಗ್ಯಾಂವಿಶಿಂ, ಆನಿ ಥಂಯ್ಚ್ಯಾ ಲೋಕಾವಿಶಿಂ, ಜೀವನ್ ಶೈಲೆವಿಶಿಂ ವರ್ಣನ್ ಕೆಲ್ಲೆಂ, ತರ್ ಚಡ್ ಸೊಭ್ತೆಂ ಮ್ಹಣ್ ಮ್ಹಜಿ ಅಭಿಪ್ರಾಯ್.